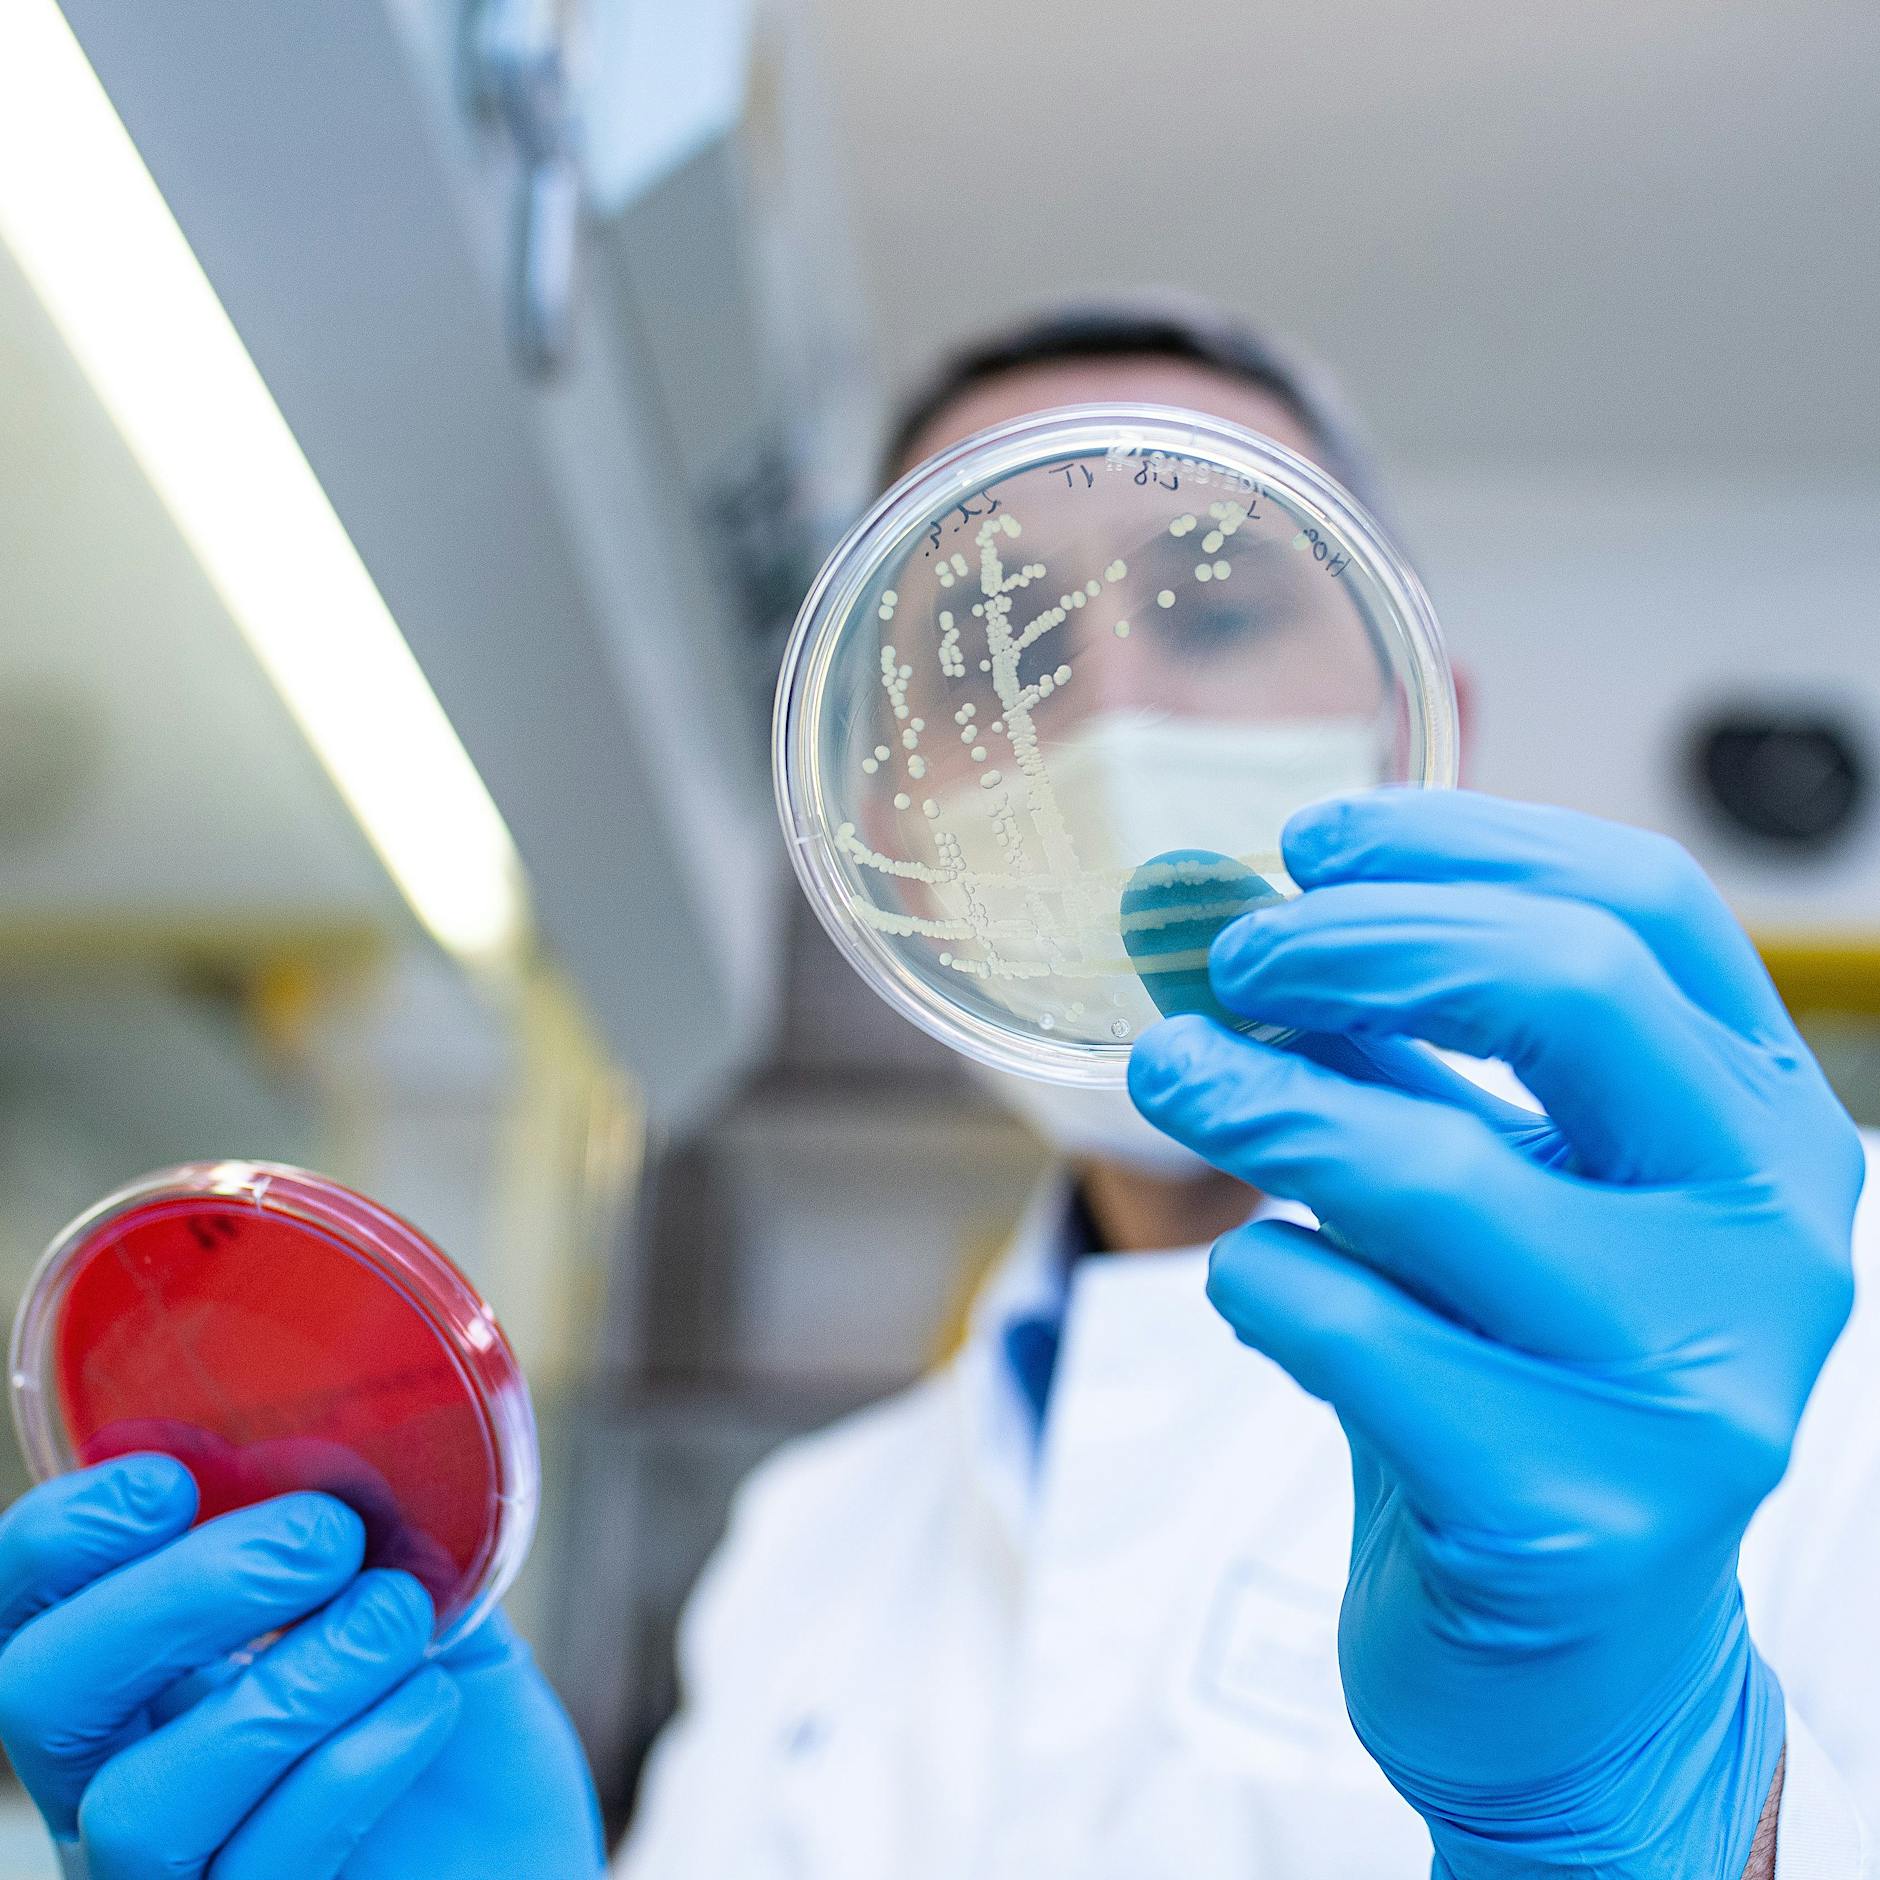
EHEC: Deutlicher Anstieg von Fällen der Darmkrankheit in Berlin

In der Hauptstadt sind in diesem Jahr vergleichsweise viele Menschen an einer Lebensmittelinfektion erkrankt. Bisher wurden insgesamt 525 Fälle von Salmonellose registriert, wie es in dem aktuellen Epidemiologischen Wochenbericht des Landesamtes für Gesundheit und Soziales (Lageso) heißt. Der Median der Jahre 2015 bis 2019 – von der ersten bis zur aktuellen Meldewoche – lag bei 418.
Demnach wurden in dieser Woche gleich mehrere Fälle von Salmonellose gemeldet. Es handelt sich bei den Erkrankten um eine männliche und fünf weibliche Personen im Alter zwischen 25 und 75 Jahren. Drei Personen wurden aufgrund der Infektion stationär in einem Krankenhaus behandelt. Drei dieser Personen haben sich außerdem womöglich im Ausland angesteckt.
Wo in Berlin die meisten Salmonellose-Fälle gemeldet werden
Den Angaben zufolge nimmt allerdings sowohl der wöchentliche als auch der generelle Trend ab. Die Fälle betreffen dabei laut dem Lageso fast alle Berliner Bezirke. Die meisten Meldungen stammen demnach aus Tempelhof-Schöneberg mit 17 Fällen, darauf folgt Mitte mit neun Fällen und Neukölln mit sechs Fällen. Aus Charlottenburg-Wilmersdorf und Spandau kommen jeweils vier Meldungen. Reinickendorf und Steglitz-Zehlendorf meldeten jeweils drei Fälle und Friedrichshain-Kreuzberg sowie Pankow jeweils zwei. In Marzahn-Hellersdorf und Lichtenberg wurde jeweils ein Fall gemeldet.
Bakterien der Gattung Salmonella können Durchfall auslösen und sind weitverbreitet. In Deutschland gehört Salmonellose neben Atemwegsinfekten zu den häufigsten Infektionskrankheiten überhaupt. Der größte Teil der Infektionen geht auf lebensmittelbedingte Infektionen zurück, besonders begünstigt durch mangelhafte Kühlung von Lebensmitteln. Laut dem Robert-Koch-Institut wird eine sichere Abtötung der Salmonellen beim Kochen bei Temperaturen über 70 Grad für mindestens zehn Minuten Garzeit erreicht. (mit dpa.)